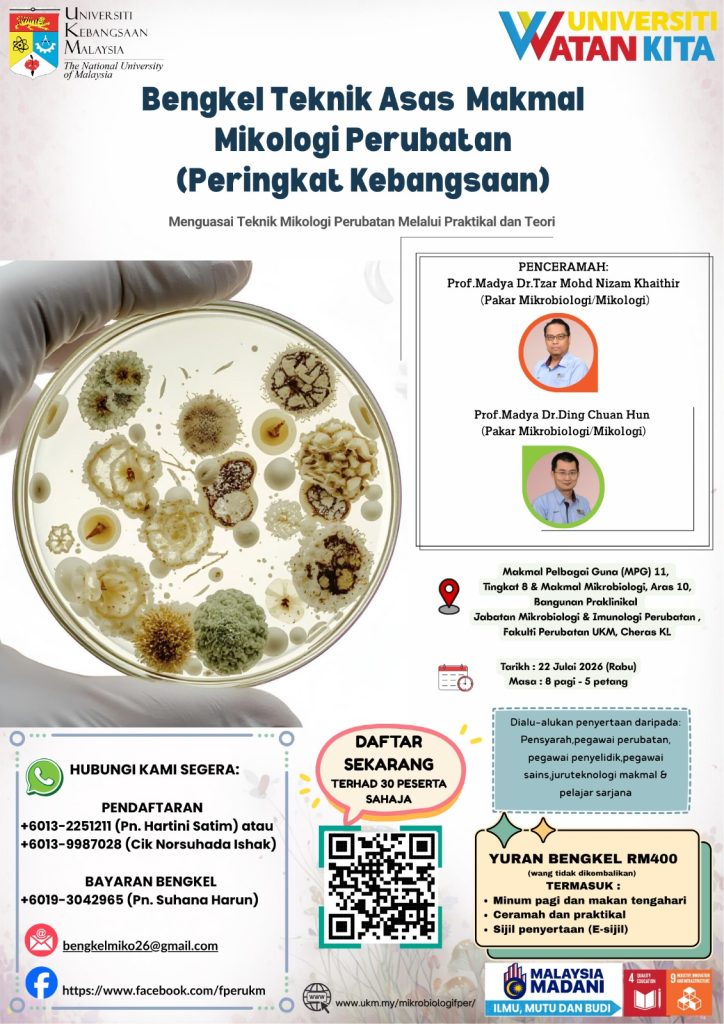

SELAMAT DATANG KE JABATAN MIKROBIOLOGI & IMUNOLOGI PERUBATAN
BERITA
Bengkel Teknik Asas Makmal Mikologi Perubatan
Bengkel ini menawarkan pendedahan menyeluruh mengenai teknik-teknik utama dalam makmal Mikologi Perubatan, termasuk kaedah kultur, pewarnaan serta teknik mikroskopi seperti lekapan basah dan kultur slaid. Selain itu, bengkel ini turut memberikan pendedahan terhadap pengurusan spesimen, merangkumi kaedah pengumpulan, penghantaran dan pemprosesan bagi memperoleh hasil ujian yang tepat dan efisien. Klik di sini untuk memuat turun brosur dan membuat pembayaran penyertaan (RM 400/ peserta). Sila klik di sini untuk melihat tentatif bengkel.
Sebarang pertanyaan boleh hubungi:
📞 0391458654 (Pn Hamidah) / 0193042965 (Pn Suhana)
Sertai Program Siswazah Kami!
Terokai dunia mikroorganisma yang menarik dan kesannya terhadap kesihatan manusia. Libatkan diri anda dalam penyelidikan terkini, teknik makmal termaju, dan pembelajaran pelbagai disiplin. Peroleh kepakaran daripada tenaga pengajar kami dan sumbangkan kepada penemuan baharu dalam pencegahan dan rawatan penyakit. Sertai kami dalam membentuk masa depan penjagaan kesihatan melalui penemuan dan kemajuan yang inovatif! Klik di sini untuk memuat turun brosur atau di sini untuk prospektus program sarjana klinikal, Doktor Pakar Patologi (Mikrobiologi Perubatan). Brosur untuk program doktor falsafah dan program sarjana sains (Mikrobiologi Perubatan) boleh didapati di sini.
Dapatkan Buku Laboratory Guide to Clinical Microbiology
Bengkel ini menawarkan pendedahan menyeluruh mengenai teknik-teknik utama dalam makmal Mikologi Perubatan, termasuk kaedah kultur, pewarnaan serta teknik mikroskopi seperti lekapan basah dan kultur slaid. Selain itu, bengkel ini turut memberikan pendedahan terhadap pengurusan spesimen, merangkumi kaedah pengumpulan, penghantaran dan pemprosesan bagi memperoleh hasil ujian yang tepat dan efisien. Klik di sini untuk memuat turun brosur dan klik di sini untuk membuat pembayaran penyertaan.
Perkhidmatan Ujian Kultur & Suseptibiliti Helicobacter pylori
Kami menawarkan perkhidmatan kultur dan ujian kerentanan Helicobacter pylori pada spesimen biopsi gastrik pesakit dari Hospital Canselor Tuanku Muhriz serta dari hospital/makmal luar. Ujian kerentanan (melalui ujian ‘minimum inhibitory concentration’) akan dilakukan terhadap antibiotik metronidazole, clarithromycin, amoxicillin, levofloxacin, tetracycline dan rifampicin. Klik di sini untuk maklumat lanjut.
Perkhidmatan Penjualan Plat Kultur & Pewarnaan Slaid
Kami menawarkan perkhidmatan penjualan plat kultur dan slaid pewarnaan untuk kegunaan pengajaran meliputi pelbagai jenis bakteria dan fungal kepada pelanggan UKM, agensi kerajaan dan agensi swasta. Klik di sini untuk maklumat lanjut.